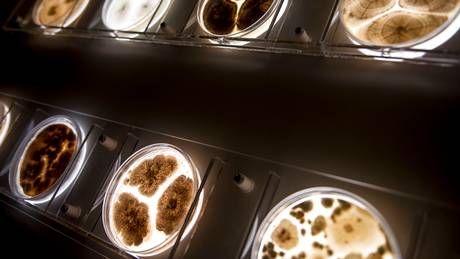
.<a href="/Novozymes/">Novozymes</a> oplever vækst i fødevaresegment buff.ly/3tlFZXt

FødevareWatch
@foedevarewatch
FødevareWatch leverer uafhængig, kritisk og fair journalistik om føde- og levnedsmiddelindustrien. Læs mere på fwatch.dk
ID: 2366487447
http://www.fodevarewatch.dk 26-02-2014 07:44:10
6,6K Tweet
1,1K Followers
490 Following





.Arla Foods rammer plet i gylden madtrend i Mellemøsten, fortæller koncerndirektør Simon Stevens. buff.ly/2ZQzoXP